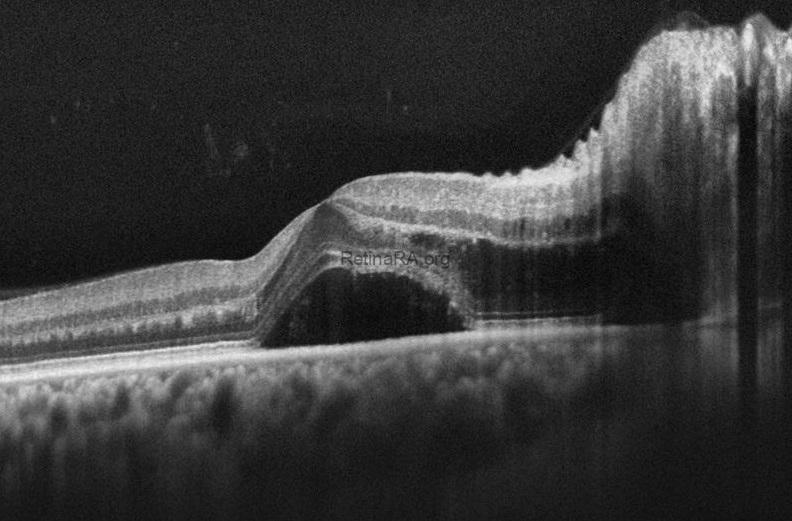
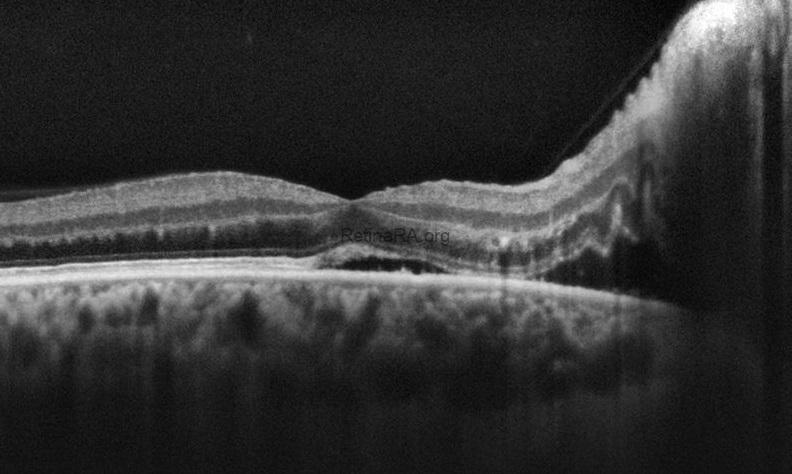
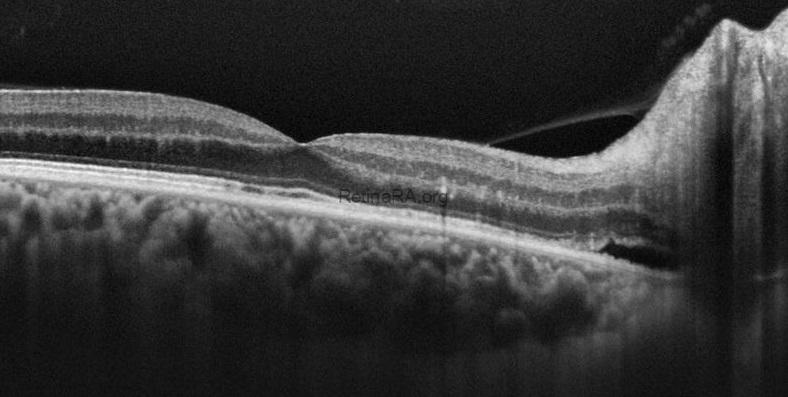

Malignant hypertension is clinically defined as severe hypertension with findings of retinal hemorrhage, optic disk swelling, and serous retinal detachment. The condition can rarely be unilateral or asymmetric. Hypertensive optic neuropathy can cause chronic optic disc swelling, leading to optic nerve atrophy and severe loss of visual acuity.
The blood pressure of this 59-year-old male patient who applied with a sudden decrease in visual acuity of the right eye (20/30) and had no known systemic disease was measured as 200/120. All systemic evaluations including blood sugar level, CRP, ESR, bartonella, toxo, etc were normal. The patient was started on antihypertensive treatment only.
Color fundus photograph of the right eye shows optic disc swelling and retinal hemorrhages (not only around the optic disc but throughout the entire macula). Retinal hemorrhages (red arrows) are also seen on color photograph of the left eye.


OCT demonstrates serous macular detachment and RNFL edema in the right eye.
Images taken nine days after the start of antihypertensive therapy show that the serous fluid decreased significantly and a half macular star (black arrow) appearance formed.

On the 20th day of treatment, the visual acuity of the right eye improved to 20/20, and serous macular detachment completely resolved. RNFL edema decreased and residual subretinal fluid was seen adjacent to the optic disc.
Why is the diagnosis not NAION?
1. VA was very good compared to NAION cases. If this patient had NAION, he would have 20/200 or worse VA. Because the whole disc appeared to be affected.
2. Retinal dot hemorrhages were seen on the macula of both eyes (the patient did not have DM).
3. If you look carefully, you can see retinal nerve fiber edema under the optic disc in the left eye. There is also a hemorrhage in the same area.
4. Final visual acuity is 20/20 and the condition resolved with only HT medication.
Credit: M. Giray Ersoz, MD, FEBO
Biruni University School of Medicine, Department of Ophthalmology, Istanbul, Turkey
Instagram accounts: @retina.review and @retina.dr.girayersoz

